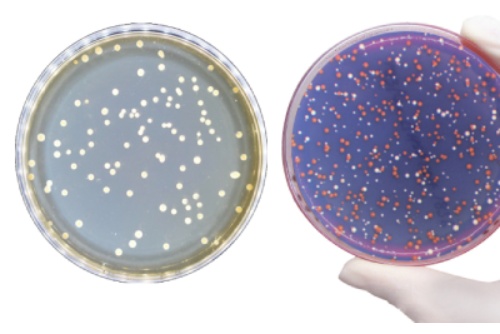

Дрожжевые экстракты, пептоны, триптоны, агары Angel Yeast (Китай) и химические компоненты питательных сред! Весь ассортимент! На складе в наличии!

Продукция Angel Yeast все больше и больше набирает популярность у наших клиентов.
Мы предлагаем продукцию китайского производителя порядка 10 лет. За это время мы наладили каналы поставок, настроили оптимальные сроки доставки. Продукция Angel Yeast всегда есть у нас на складе. Вы можете ее купить как с нашего склада, так и оставить заявку под заказ.
Представляем дополненный ассортимент высококачественных компонентов питательных сред производства Angel Yeast. Вся продукция сертифицирована по международным стандартам контроля качеством BRC, ISO 22000, HACCP, GMP. Производство Angel Yeast обладает самыми передовыми в мире технологиями и оборудованием по производству дрожжей. На предприятии применяется автоматическая интеллектуальная система контроля производства. Сочетание современных технологий, оборудования и системы контроля качества позволяет реализовывать высокую автоматизацию производственного процесса для обеспечения качества продукции.
Химические компоненты питательных сред для биотехнологии
Дрожжевые экстракты Angel Yeast
Дрожжевые экстракты Angel Yeast хорошо растворяются в воде, это делает их легкоусвояемыми для микроорганизмов и клеток, чтобы удовлетворить потребности клеток в росте, что в свою очередь улучшает накопление метаболитов. Компоненты дрожжевых экстрактов обеспечивают микроорганизмы и клетки необходимыми питательными веществами, такими как витамины, микроэлементы, факторы роста, аминокислоты и пептиды со сбалансированным составом, которые способствуют увеличивают роста биомассы и синтезу продукта.

Основные преимущества дрожжевых экстрактов Angel Yeast
- Стабильное качество;
- без ГМО;
- без компонентов животного происхождения;
- не вызывают аллергии;
- строгая система контроля качества;
- высокая производительность ;
- хорошая растворимость;
- сбалансированный состав питательных веществ;
- усовершенствованная технология производства.
Области применения дрожжевых экстрактов Angel Yeast
Сельскохозяйственная и природоохранная промышленность

- Биопестициды.
- Биоинсектициды.
- Биопластик.
- Биоремедиация.
- Пробиотики для сельского хозяйства, окружающей среды.
Молочная промышленность

- Закваска.
- Йогурт и пробиотический напиток.
- Пробиотики для здоровья человека и корма для животных.
- Выращивание грибов и макрогрибов.
Биологически активные молекулы и химическая промышленность

- Ферменты-гормоны.
- Органические кислоты-витамины.
- Антибиотики.
- Аминокислоты и пептиды.
- Другой тип крупномасштабной ферментации.
Индустрия питательных сред и лабораторной диагностики
- Лабораторные исследования.
- Обезвоженные питательные среды.
- Диагностика.
В ассортименте представлен широкий выбор дрожжевых экстрактов, мясных и рыбных пептонов, триптонов:
В нашем ассортименте продукции появилась новинка: агар-агары разной плотности и отдельные химические компоненты для питательных сред, такие как нитраты, фосфаты, микроэлементы и прочее, которые помогут Вам создать идеальную сбалансированную питательную среду для полноценного культивирования самых разных микроорганизмов.
|
3369.0500
|
|
500 г
|
5 449
5 449 AMD
|
|
|
||||||||||||||||||||||||
|
Производится из автолизата отборных штаммов дрожжей S. cerevisiae; пептон дрожжевой служит источником азота свободных аминокислот, пептидов, витаминов, и микроэлементов; используется для приготовления питательных сред, в пищевой промышленности, при производстве пробиотиков, биопрепаратов, ферментов и других био-продуктов. |
|||||||||||||||||||||||||||||
|
3369.20000
|
|
|
По запросу По запросу |
|
|
||||||||||||||||||||||||
|
3016.0500
|
|||||||||||||||||||||||||||||
|
Производится из автолизата отборных штаммов дрожжей S. cerevisiae; пептон дрожжевой служит источником азота свободных аминокислот, пептидов, витаминов, и микроэлементов; используется для приготовления питательных сред, в пищевой промышленности, при производстве пробиотиков, биопрепаратов, ферментов и других био-продуктов.
|
|||||||||||||||||||||||||||||
|
3017.0500
|
|||||||||||||||||||||||||||||
|
Производится из автолизата отборных штаммов дрожжей S. cerevisiae; обладает хорошей растворимостью, высокой степенью прозрачности и низким содержанием эндотоксинов; служит источником свободных аминокислот, пептидов, витаминов, и микроэлементов; применяется для приготовления питательных сред, в пищевой промышленности, при производстве пробиотиков, биопрепаратов, ферментов и других био-продуктов.
|
|||||||||||||||||||||||||||||
|
3475.0200
|
|||||||||||||||||||||||||||||
|
3369.5000
|
|
|
28 234
28 234 AMD
|
|
|
||||||||||||||||||||||||
|
|
|||||||||||||||||||||||||||||
|
3394.0500
|
|||||||||||||||||||||||||||||||||||||||
|
Автолизированные дрожжевые препараты получают путем искусственного автолиза неактивных дрожжей Saccharomyces cerevisiae при температуре 50-60 °C. В ходе этой процедуры происходит разрушение клеточных стенок дрожжей с высвобождением содержащихся в них органических и неорганических веществ. Под действием гидролитических ферментов дрожжевой белок расщепляется на отдельные пептиды и аминокислоты, молекулы которых формируют основу т. н. автолизата.
Дрожжевые автолизаты находят применение в производстве биологически активных добавок (БАД) к пище и кормам для сельскохозяйственных животных, а также микробиологических сред и бульонов, используемых для выращивания широкого спектра микроорганизмов.
|
|||||||||||||||||||||||||||||||||||||||
|
3394.5000
|
|
|
По запросу По запросу |
|
|
||||||||||||||||||||||||||||||||||
|
|
|||||||||||||||||||||||||||||||||||||||
|
3393.0500
|
|||||||||||||||||||||||||||||||||
|
Препараты неактивных дрожжей Saccharomyces cerevisiae находят широкое применение в виноделии, производстве микробиологических сред и биологически активных добавок (БАД) к пище и кормам для сельскохозяйственных животных. Помимо этого их нередко используют в биоремедиации объектов окружающей среды от тяжелых металлов, биологическом контроле качества стерилизации, при изучении биотрансформации органических субстратов, лекарственных средств и пр.
|
|||||||||||||||||||||||||||||||||
|
|
|||||||||||||||||||||||||||||||||
|
3338.0500
|
|||||||||||||||||||||||||||||||||||||||
|
Пептон мясной бактериологический является панкреатическим гидролизатом животных тканей, обогащенный факторами роста, предназначенные для применения в диагностике.
|
|||||||||||||||||||||||||||||||||||||||
|
4037.0500
|
|
|
4 589
4 589 AMD
|
|
|
||||||||||||||||||||||||||||||||||
|
4037.5000
|
|
|
45 348
45 348 AMD
|
|
|
||||||||||||||||||||||||||||||||||
|
4037.20000
|
|
|
По запросу По запросу |
|
|
||||||||||||||||||||||||||||||||||
|
|
|||||||||||||||||||||||||||||||||||||||
|
3354.0500
|
|||||||||||||||||||||||||||||||||||||
|
|||||||||||||||||||||||||||||||||||||
|
|
|||||||||||||||||||||||||||||||||||||
|
3313.0100
|
|||||||||||||||||||||||||||||||||||||
|
|||||||||||||||||||||||||||||||||||||
|
|
|||||||||||||||||||||||||||||||||||||


Агар-агары
Мы рады представить новые высококачественные агар-агары китайского производства для применения в бактериологи и биотехнологии, а также для микроклонального размножения растений в качестве загустителя питательных сред.
Агары уже протестированы нашими клиентами, поэтому мы можем быть уверены в их проверенном качестве. Агары для бактериологии имеют различные параметры прочности геля: 700, 750 и 1000 г/см².
Агар-агары для растений проходят строгий контроль и разработаны специально для получения высокого урожая при микроклональном размножении растений. Все агары в наличии на складе, имеются различные варианты фасовок: 500 г, 5 кг и 25 кг.
|
4075.0500
|
|
|
12 687
12 687 AMD
|
|
|
||||||
|
4075.5000
|
|
|
108 672
108 672 AMD
|
|
|
||||||
|
4075.25000
|
|
|
По запросу По запросу |
|
|
||||||
|
4074.0500
|
|
|
13 496
13 496 AMD
|
|
|
||||||
|
4074.5000
|
|
|
127 135
127 135 AMD
|
|
|
||||||
|
4074.25000
|
|
|
По запросу По запросу |
|
|
||||||
|
3474.1000
|
|
|
28 666
28 666 AMD
|
|
|
||||||
|
3474.5000
|
|
|
183 965
183 965 AMD
|
|
|
||||||
|
3474.25000
|
|
|
По запросу По запросу |
|
|
||||||
|
3474.0500
|
|
|
14 576
14 576 AMD
|
|
|
||||||
|
|
|||||||||||
Химические компоненты питательных сред для биотехнологии
Чтобы список компонентов для биотехнологии был полон, мы подобрали химические реактивы, которые используются в рецептурах питательных сред для культивирования как в малых лабораторных объемах, так и в производственных.
Мы подобрали реактивы индийского и российского производства, но также имеются и европейские, качество в соотношении цены которых оптимально подходят для бактериального клеточного культивирования в биологических реакторах (ферментёрах), шейкерах-инкубаторах.
Указаны небольшие фасовки, при необходимости использования больших объемов – сообщите, мы направим Вам предложение. При необходимости поддержания реактивов на складе на регулярной основе, также сообщите нам и мы сможем сделать для Вас индивидуальную программу поддержки реактивов по заранее согласованному графику поставок.
- На складе
- В транзите
- В транзите и на складе
- Все товары
|
Компонент-Реактив
|
|||||||||||||||||||||||||||||||||||||||||||||||||||||||
|
3849.1000
|
|
1 кг
|
5 659
5 659 AMD
|
|
|
||||||||||||||||||||||||||||||||||||||||||||||||||
|
Синоним: cульфат аммония, аммонийная соль серной кислот.
|
|||||||||||||||||||||||||||||||||||||||||||||||||||||||
|
027202.500 gm
|
|
|
1 670
1 670 AMD
|
|
|
||||||||||||||||||||||||||||||||||||||||||||||||||
|
027149.500 gm
|
|
|
2 134
2 134 AMD
|
|
|
||||||||||||||||||||||||||||||||||||||||||||||||||
|
027153.500 gm
|
|
|
10 324
10 324 AMD
|
|
|
||||||||||||||||||||||||||||||||||||||||||||||||||
|
037020.100 gm
|
|
|
8 253
8 253 AMD
|
|
|
||||||||||||||||||||||||||||||||||||||||||||||||||
|
037020.25 gm
|
|
|
2 631
2 631 AMD
|
|
|
||||||||||||||||||||||||||||||||||||||||||||||||||
|
024060.100 mg
|
|
|
транспортировка +2...+8 °C
|
802
802 AMD
|
|
|
|||||||||||||||||||||||||||||||||||||||||||||||||
|
027410.25 kg
|
|
|
По запросу По запросу |
|
|
||||||||||||||||||||||||||||||||||||||||||||||||||
|
027410.5 kg
|
|
|
26 826
26 826 AMD
|
|
|
||||||||||||||||||||||||||||||||||||||||||||||||||
|
027410.500 gm
|
|
|
3 525
3 525 AMD
|
|
|
||||||||||||||||||||||||||||||||||||||||||||||||||
|
537055.1 lit
|
|
|
8 963
8 963 AMD
|
|
|
||||||||||||||||||||||||||||||||||||||||||||||||||
|
506250.5 kg
|
|
|
19 596
19 596 AMD
|
|
|
||||||||||||||||||||||||||||||||||||||||||||||||||
|
506250.500 gm
|
|
|
3 275
3 275 AMD
|
|
|
||||||||||||||||||||||||||||||||||||||||||||||||||
|
506250.25 kg
|
|
|
61 812
61 812 AMD
|
|
|
||||||||||||||||||||||||||||||||||||||||||||||||||
|
PCT1603.1 kg
|
|
|
5 688
5 688 AMD
|
|
|
||||||||||||||||||||||||||||||||||||||||||||||||||
|
103795.50 kg
|
|
|
По запросу По запросу |
|
|
||||||||||||||||||||||||||||||||||||||||||||||||||
|
044045.500 gm
|
|
|
хранение +2...+8°C, транспортировка +4°C
|
13 290
13 290 AMD
|
|
|
|||||||||||||||||||||||||||||||||||||||||||||||||
|
528620.500 gm
|
|
|
4 264
4 264 AMD
|
|
|
||||||||||||||||||||||||||||||||||||||||||||||||||
|
029581.500 gm
|
|
|
4 698
4 698 AMD
|
|
|
||||||||||||||||||||||||||||||||||||||||||||||||||
|
195945.500 gm
|
|
|
3 337
3 337 AMD
|
|
|
||||||||||||||||||||||||||||||||||||||||||||||||||
|
3863.1000
|
|
|
7 381
7 381 AMD
|
|
|
||||||||||||||||||||||||||||||||||||||||||||||||||
|
029630.100 gm
|
|
|
26 826
26 826 AMD
|
|
|
||||||||||||||||||||||||||||||||||||||||||||||||||
|
029608.500 gm
|
|
|
5 872
5 872 AMD
|
|
|
||||||||||||||||||||||||||||||||||||||||||||||||||
|
LC-4505.1
|
|
|
52 419
52 419 AMD
|
|
|
||||||||||||||||||||||||||||||||||||||||||||||||||
|
027580.500 gm
|
|
|
488 317
488 317 AMD
|
|
|
||||||||||||||||||||||||||||||||||||||||||||||||||
|
3425.1000/LC-5065.1000
|
|||||||||||||||||||||||||||||||||||||||||||||||||||||||
|
|||||||||||||||||||||||||||||||||||||||||||||||||||||||
|
027984.500 gm
|
|
|
4 386
4 386 AMD
|
|
|
||||||||||||||||||||||||||||||||||||||||||||||||||
|
LC-4501.4
|
|
|
По запросу По запросу |
|
|
||||||||||||||||||||||||||||||||||||||||||||||||||
|
Импорт
|
|||||||||||||||||||||||||||||||||||||||||||||||||||||||
|
1534.1000/LC-12000.1000
|
|||||||||||||||||||||||||||||||||||||||||||||||||||||||
|
|||||||||||||||||||||||||||||||||||||||||||||||||||||||
|
Компонент-Реактив
|
|||||||||||||||||||||||||||||||||||||||||||||||||||||||
|
3834.1000
|
|
1 кг
|
4 975
4 975 AMD
|
|
|
||||||||||||||||||||||||||||||||||||||||||||||||||
|
Импорт
|
|||||||||||||||||||||||||||||||||||||||||||||||||||||||
|
LC-4570.1
|
|||||||||||||||||||||||||||||||||||||||||||||||||||||||
|
Химическая формула NaOH
CAS-No.: 1310-73-2 |
|||||||||||||||||||||||||||||||||||||||||||||||||||||||
|
Компонент-Реактив
|
|||||||||||||||||||||||||||||||||||||||||||||||||||||||
|
3848.0500
|
|||||||||||||||||||||||||||||||||||||||||||||||||||||||
|
Синоним: натрий ацетат 3 водный, натрий уксуснокислый.
|
|||||||||||||||||||||||||||||||||||||||||||||||||||||||
|
3436.1000
|
|||||||||||||||||||||||||||||||||||||||||||||||||||||||
|
030123.500 gm
|
|
|
1 578
1 578 AMD
|
|
|
||||||||||||||||||||||||||||||||||||||||||||||||||
|
044069.100 gm
|
|
|
3 624
3 624 AMD
|
|
|
||||||||||||||||||||||||||||||||||||||||||||||||||
|
044069.25 gm
|
|
|
По запросу По запросу |
|
|
||||||||||||||||||||||||||||||||||||||||||||||||||
|
Диаэм
|
|||||||||||||||||||||||||||||||||||||||||||||||||||||||
|
3492.0250/LC-10072.0250
|
|||||||||||||||||||||||||||||||||||||||||||||||||||||||
|
|||||||||||||||||||||||||||||||||||||||||||||||||||||||
|
neoFroxx
|
|||||||||||||||||||||||||||||||||||||||||||||||||||||||
|
LC-10054.1
|
|
1 л
|
По запросу По запросу |
|
|
||||||||||||||||||||||||||||||||||||||||||||||||||
|
Синоним: Полисорбат 80.
|
|||||||||||||||||||||||||||||||||||||||||||||||||||||||
|
LC-10054.2
|
|
|
По запросу По запросу |
|
|
||||||||||||||||||||||||||||||||||||||||||||||||||
|
037156.100 gm
|
|
|
6 056
6 056 AMD
|
|
|
||||||||||||||||||||||||||||||||||||||||||||||||||
|
937600.100 gm
|
|
|
2 542
2 542 AMD
|
|
|
||||||||||||||||||||||||||||||||||||||||||||||||||
|
|
|||||||||||||||||||||||||||||||||||||||||||||||||||||||
Ниже вы можете задать вопрос или оставить запрос в свободной форме:
Все поля со звездочкой (*) обязательны для заполнения
Данное действие необратимо.
чтобы сделать работу на сайте еще удобнее!
С помощью личного кабинета Вы сможете:
- моментально получать счета на оформленные заказы;
- отслеживать статусы выполнения заказа по оплате, отгрузке, наличию товаров на складе;
- вести историю заказов, повторять заказы полностью или частично;
- выбирать персонального менеджера;
- формировать списки избранного среди товаров, справочных материалов и видео;
- делать заказ со страницы избранных товаров;
- экономить время при заполнении форм заказа по каталогам и регистрации на мероприятия.

